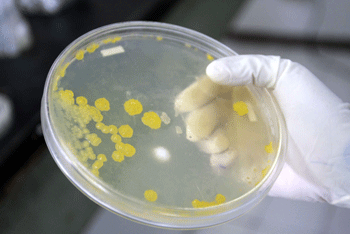

| Año 8 • No. 319 • Julio 21 de 2008 | Xalapa • Veracruz • México |
Publicación
Semanal
|
![]()
Centrales
Editorial
General
Entrevista
Regiones
Becas
y oportunidades
Arte
Deportes
Contraportada
Del
municipio de Banderilla Confirman existencia de escherichia coli y pseudomonas en manantiales Alma Espinosa |
||
| Magdiel
Ramírez del IIB-UV realizó la investigación. Otras bacterias encontradas fueron: proteus y clepsiela Los resultados serán entregados a las autoridades municipales y a lugareños |
||
|
||
| A
pesar de lucir cristalina, el agua de los manantiales de Banderilla
no puede ingerirse sin algún tipo de tratamiento debido a los
altos contenidos de contaminantes; por ello, Magdiel Alejandra Ramírez
Barragán, egresada de la Facultad de Biología de la
Universidad Veracruzana (UV), desarrolla un estudio completo. Como parte de su trabajo recepcional para titularse, la joven tomó muestras para determinar qué tipo de microorganismos contienen los manantiales que posteriormente desembocan en el río Sedeño, y cuál es la fórmula idónea que debe utilizarse para que las personas de los alrededores la tomen sin tener consecuencias. |
||
|
Magdiel
Ramírez, quien actualmente desarrolla su investigación
en el Instituto de Investigaciones Biológicas de la UV, informó
que el estudio que realiza busca ayudar a las personas a que no
contraigan enfermedades por ingerir agua con bacterias. Para ello
le proporcionará los resultados a los lugareños y
a las autoridades de Banderilla.
Mensualmente colectó muestras para hacer la detección de coliformes totales y fecales y en el laboratorio realizó una siembra selectiva para adquirir bacterias. Su objetivo inicial era observar cinco géneros de bacterias patógenas que tienen mayor incidencia en la población, éstos son: salmonela, shigella, pseudomona, escherichia coli y vibrio. |
Magdiel Alejandra Ramírez Barragán, egresada de la Facultad de Biología de la UV |
|
|
Hasta el momento sólo ha encontrado escherichia coli y pseudomona;
sin embargo, ha localizado otros géneros que quizá no
tienen la misma incidencia o importancia clínica que las mencionadas,
pero sí causan enfermedades. Algunas de las bacterias encontradas
son proteus y clepsiela. En entrevista comentó que inició la investigación porque no le bastaba saber que en los manantiales se encuentran coliformes totales y fecales en cantidades pequeñas. Nadie le garantizaba que otros microorganismos también estaban presentes en las mismas cantidades, sobre todo porque la gente ni siquiera hierve el agua que toma y que proviene de los manantiales. Para asegurarse que hay presencia de bacterias debe realizar varias siembras en medios específicos. “Después que siembre en todos los agares que me sugieren, para estar segura que los resultados me envían a un género, les hago pruebas específicas. Dejo que por unos días crezca la bacteria, le agrego soluciones y posteriormente le hago pruebas como de movilidad”, expresó. |
||
|
|
||

